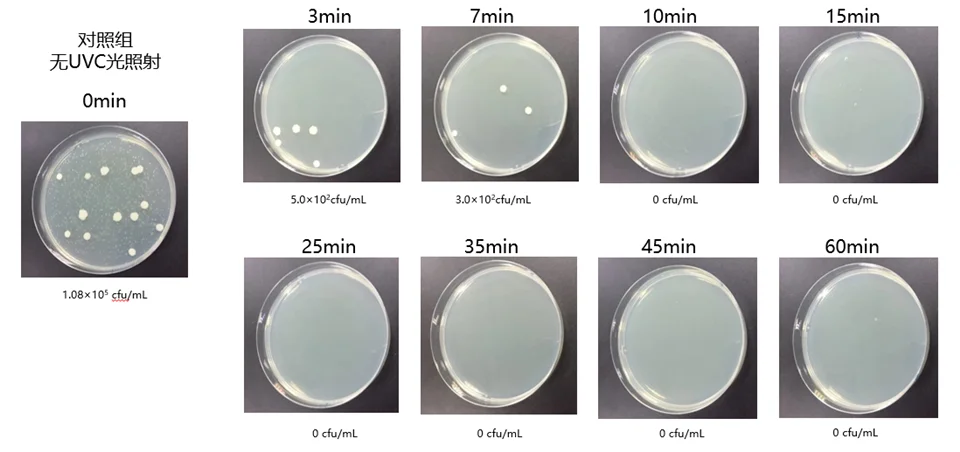
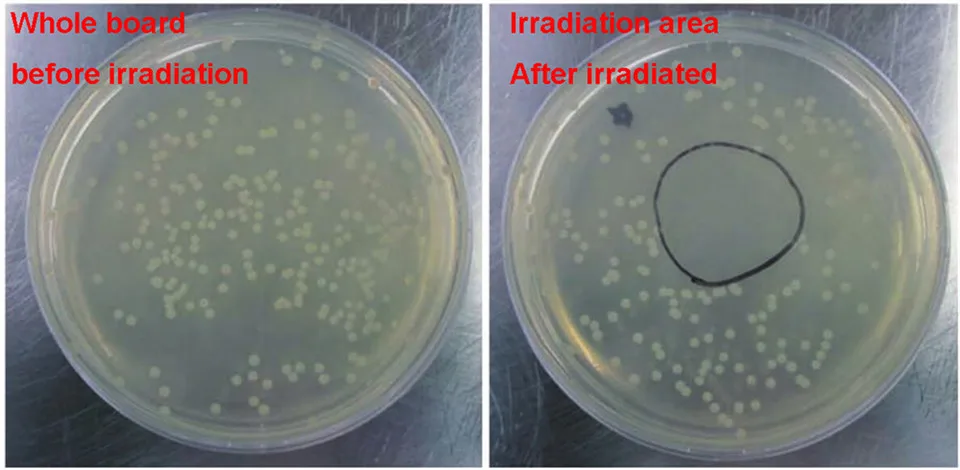

10 шт 9V 275nm 5W UVC Светодиодный модуль для УФ-лампа для гидравлических стерилизационных UVC насыщенного фиолетового ультрафиолетовый светильник для стерилизации с бесплатной доставкой
5 571,39₽
В наличии!
LucBei Factory Discount Store - Надежность 71.5%
Более 58 подписчиков, дата открытия магазина 08.08.2018
- Положительные оценки: 0% (0)
- Соответствие описанию: 96%
- Отвечает на сообщения: 96%
- Скорость отправки: 94%
Последнее обновление: 19.09.2024
Последнее обновление: 24.05.2022
Высококачественный светодиодный модуль UVC 9 в нм 5 Вт для УФ-лампы...
1 362,23₽
Последнее обновление: 17.03.2022
Высококачественный USB 275nm 5 Вт UVC светодиодный модуль УФ лампа ...
928,86₽
Последнее обновление: 13.10.2024
УФ-лампа для стерилизации, 4 Вт, 10 шт., 6 в, вход UVC 275nm
4 710,06₽
Последнее обновление: 13.10.2024
Эксперимент по облучению парамецитом
Для того, чтобы уменьшить ваше время и экономические потери, пожалуйста, введите в строке поиска на проверяйте светодиодный введение UVC светодиодный размерную сетку США самостоятельно.Настоящий светодиодный UVC может излучать Только слабый светильник. UVC обеспечивает эффект стерилизации через лучистую энергию, а не прочность светильник, чтобы определить UVC!Если вам нужны более подробные отчеты об испытаниях и таблицы данных, пожалуйста, свяжитесь с нами, и я пришлю вам электронное письмо.Если вам нужно большое количество заказов, пожалуйста, свяжитесь с нами, чтобы узнать цену оптовых покупок.

Вопросы еще не задавались...
-
Вес логистики0.500
-
Гарантия3 year
-
Каждая упаковка10
-
Минимальная единица измерения100000015
-
Название брендаLucBei
-
Напряжение12 В
-
Номер моделиUVC LED Module
-
Продано Вsell_by_lot
-
ПроисхождениеКитай
-
Размер логистики - высота (см)2
-
Размер логистики - длина (см)8
-
Размер логистики - ширина (см)9
-
Световой Поток40-50mW
-
СертификацияЕвропейский сертификат соответствия
-
Средний срок службы (час)50000
-
Темп. Цвета (K)275
-
Тип товараУльтрафиолетовые лампы
-
ХарактеристикиDisinfect





